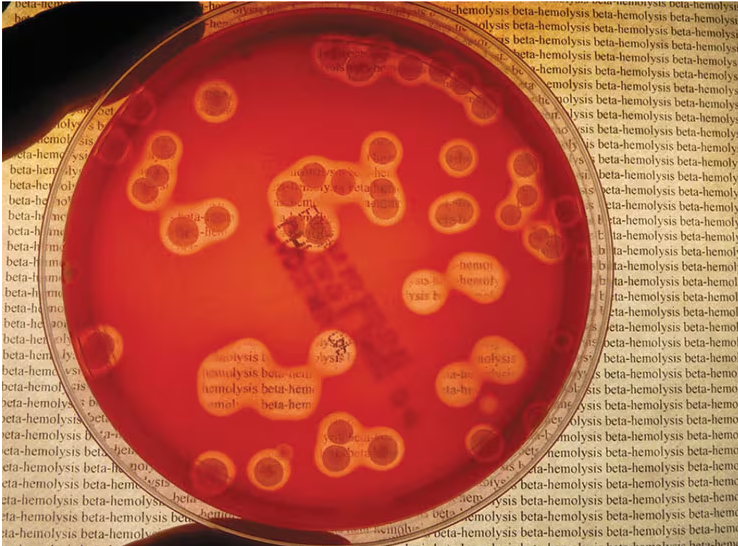
Petri dish showing clear zones around Staphylococcus aureus colonies indicating beta-hemolysis on blood agar.

Back
BackProblem 1
Label each of these thioglycolate tubes to indicate the oxygen requirements of the microbes growing in them.
Problem 1
All cells require a source of ___________ for redox reactions.
Problem 1
High temperature affects the shape of particular molecules. How does this affect the life of a microbe?
Problem 2
Support or refute the following statement: Microbes cannot tolerate the low pH of the human stomach.
Problem 2
A toxic form of oxygen,___________ oxygen, is molecular oxygen with electrons that have been boosted to a higher energy state.
Problem 2
“In the laboratory, a sterile inoculating loop is moved across the agar surface in a culture dish, thinning a sample and isolating individuals.” This statement describes which of the following?
a. Broth culture
b. Pour plate
c. Streak plate
d. Dilution plate
Problem 2
Describe the type of hemolysis shown by the pathogen Staphylococcus aureus pictured here.
Problem 3
All cells recycle the essential element ___________ from amino acids and nucleotides.
Problem 3
Explain quorum sensing, and describe how it is related to biofilm formation.
Problem 3
Superoxide dismutase:
a. Causes hydrogen peroxide to become toxic
b. Detoxifies superoxide radicals
c. Neutralizes singlet oxygen
d. Is missing in aerobes
Problem 4
The most reactive of the four toxic forms of oxygen is:
a. The hydroxyl radical
b. The peroxide anion
c. The superoxide radical
d. Singlet oxygen
Problem 4
___________ are small organic molecules that are required in minute amounts for metabolism.
Problem 4
Why must media, vessels, and instruments be sterilized before they are used for microbiological procedures?
Problem 5
The lowest temperature at which a microbe continues to metabolize is called its ___________ .
Problem 5
Microaerophiles that grow best with a high concentration of carbon dioxide in addition to a low level of oxygen are called:
a. Aerotolerant
b. Capnophiles
c. Facultative anaerobes
d. Fastidious
Problem 5
Why is agar used in microbiology?
Problem 6
Which of the following is not a growth factor for various microbes?
a. Cholesterol
b. Water
c. Vitamins
d. Heme
Problem 6
What is the difference between complex media and defined media?
Problem 6
Cells that shrink in hypertonic solutions such as saltwater are responding to ___________ pressure.
a. Optimum growth temperature
b. Maximum growth temperature
c. Minimum growth temperature
d. Metabolic threshold
Problem 7
Organisms that preferentially may thrive in icy waters are described as:
a. Barophiles
b. Thermophiles
c. Mesophiles
d. Psychrophiles
Problem 7
Draw and label the four distinct phases of a bacterial growth curve. Describe what is happening within the culture as it passes through the phases.
Problem 7
Obligate ___________ exist in salt ponds because of their ability to withstand high osmotic pressure.
Problem 8
If there are 47 cells in 1 μl of sewage, how many cells are there in a liter?
Problem 8
___________ pigments protect many phototrophic organisms from photochemically produced singlet oxygen.
Problem 8
Barophiles:
a. Cannot cause diseases in humans
b. Live at normal barometric pressure
c. Die if put under high pressure
d. Thrive in warm air
Problem 9
List three indirect methods of counting microbes.
Problem 9
Which of the following terms best describes an organism that cannot exist in the presence of oxygen?
a. Obligate aerobe
b. Facultative aerobe
c. Obligate anaerobe
d. Facultative anaerobe
Problem 10
In a defined medium:
a. The exact chemical composition of the medium is known
b. Agar is available for microbial nutrition
c. Blood may be included
d. Organic chemicals are excluded
Problem 10
A student observes a researcher streaking a plate numerous times, flaming the loop between streaks. The researcher is likely using the ___________ method to isolate microorganisms.
Problem 10
List five direct methods of counting microbes.